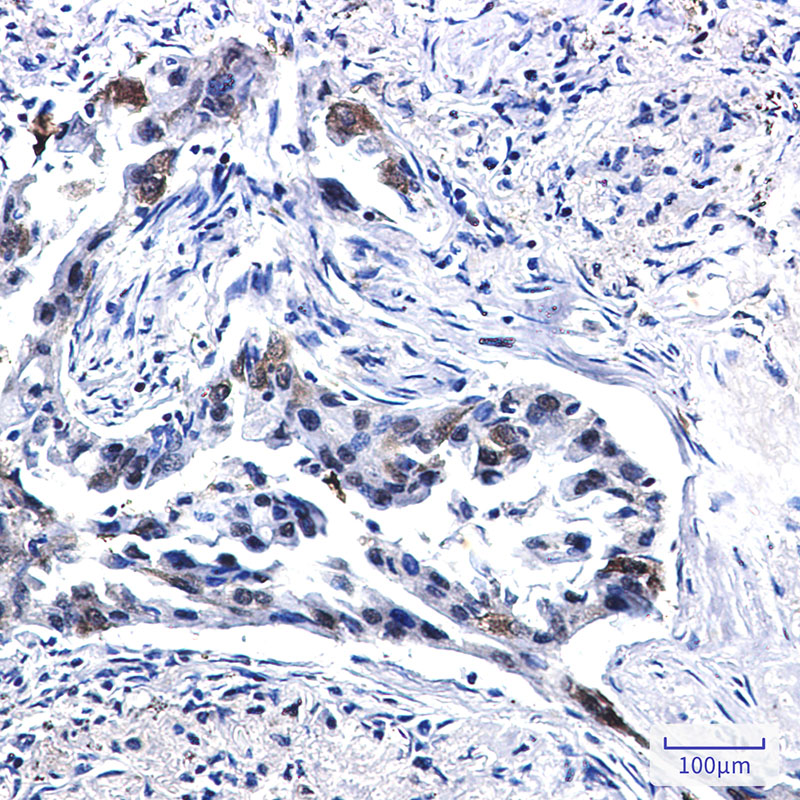

-
分类: 科研抗体货号: P22169别名: VTN; Vitronectin; VN; S-protein; Serum-spreading factor; V75应用: WB,IHC,IF反应种属: Human
-
分类: 科研抗体货号: P22184别名: YAP1; YAP65; Yorkie homolog; 65 kDa Yes-associated protein; YAP65应用: WB,IP,IHC反应种属: Human
-
分类: 科研抗体货号: P22201别名: CD365; HAVCR 1; HAVCR; Havcr1; KIM 1; TIM; TIM1; TIMD1应用: WB反应种属: Human,Mouse,Rat
-
分类: 科研抗体货号: P22168别名: VCL; Vinculin; Metavinculin应用: WB,IHC反应种属: Human,Mouse,Rat
-
分类: 科研抗体货号: P22183别名: YAP1; YAP65; Yorkie homolog; 65 kDa Yes-associated protein; YAP65应用: WB,IF反应种属: Human,Mouse
-
分类: 科研抗体货号: P22200别名: F3; Tissue factor; TF; Coagulation factor III; Thromboplastin; CD antigen CD142应用: WB,IHC反应种属: Human,Mouse,Rat
-
分类: 科研抗体货号: P22182别名: BTF2 p80; COFS2; CXPD; EM9; ERCC2; MAG; TFIIH p80; TTD; XPD; XPDC应用: WB,IF反应种属: Human
-
分类: 科研抗体货号: P22166别名: VIL; VIL1; Villin1应用: WB,IP,IHC反应种属: Human
-
分类: 科研抗体货号: P22199别名: BSG; Basigin; 5F7; Collagenase stimulatory factor; Extracellular matrix metalloproteinase inducer; EMMPRIN; Leukocyte activation antigen M6; OK blood group antigen; Tumor cell-derived collagenase stimulatory factor; TCSF; CD antigen CD147应用: WB,IHC,IF反应种属: Human
-
分类: 科研抗体货号: P22181别名: Cernunno; Nhej1; Non homologous end joining factor 1; Protein cernunnos; XLF; XRCC4 like factor应用: WB反应种属: Human,Mouse,Rat

鄂公网安备42018502007531号
鄂公网安备42018502007531号

